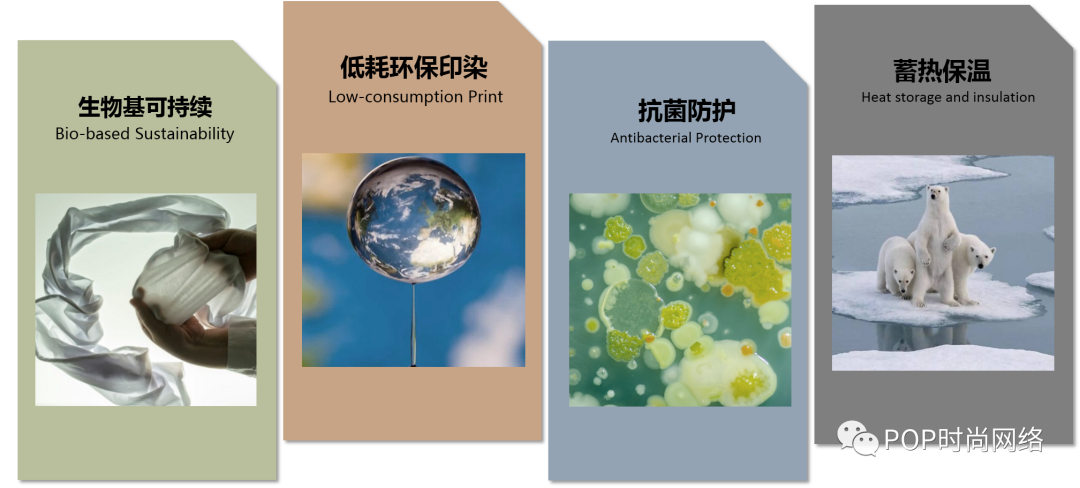

2021-05-18
【OUE職業(yè)裝·團(tuán)服展】在如今的服飾審美當(dāng)中,曾被視為褐衣的粗布麻材質(zhì)服裝如今可謂是頗具時(shí)尚范。小到棉麻小物件、擺件,大到以棉···
2021-05-17
【OUE職業(yè)裝·團(tuán)服展】發(fā)展生物質(zhì)經(jīng)濟(jì)已經(jīng)成為一種必然需要!功能紡織獲悉:近日,福建鳳竹紡織科技股份有限公司“大麻混紡針織面料···
2021-05-14
【OUE職業(yè)裝·團(tuán)服展】夏天,防曬是最熱的討論話題之一,專業(yè)戶外品牌CAMEL駱駝打造首屆駱駝防曬節(jié),通過(guò)自主研發(fā)的防曬科技產(chǎn)品宣發(fā)、全媒體線上推廣、全渠道種草,并與丸美進(jìn)行聯(lián)名跨···
2021-05-13
【OUE職業(yè)裝·團(tuán)服展】面對(duì)來(lái)自社會(huì)、政治、環(huán)境和經(jīng)濟(jì)的挑戰(zhàn),消費(fèi)者將在2022/23年逐漸養(yǎng)成日常療愈的習(xí)慣。工程產(chǎn)品、食品及材料領(lǐng)域的技術(shù)發(fā)展將日益呈現(xiàn)商業(yè)化趨勢(shì),旨在保護(hù)自然···
2021-05-12
【OUE職業(yè)裝·團(tuán)服展】法國(guó)國(guó)家海軍(La Marine nationale)日前宣布,推出旗下首個(gè)服裝品牌 Marine nationale,品牌官網(wǎng)(boutique···
2021-05-11
【OUE職業(yè)裝·團(tuán)服展】核心提示:這是一款功能性面料,COOLMAX是異形截面纖維,纖維表面形成了四道溝槽,所以纖維表面積加大,它可以利用溝槽的虹吸將體表的水分吸走,并盡快揮發(fā)掉,···
国语对白永久免费
|
婷婷中文
|
日韩欧美一级片
|
日韩久久成人
|
美女娇喘|
在线观看亚洲
|
欧美成人三区
|
亚洲深夜视频
|
成人h在线观看
|
国偷自产视频一区二区久
|
av老女人|
精品久久二区
|
秋霞av鲁丝片一区二区
|
安装下载app
|
婷婷中文|
人妻少妇精品视频一区二区三区
|
色婷婷伊人
|
久久综合社区
|
日本久久久久久久久久
|
强行糟蹋人妻hd中文
|
一级免费黄色片
|
亚洲精品小视频
|
91亚洲国产成人精品一区
|
少妇综合
|
涩涩五月天
|
欧美精品久久久久久
|
伊人网视频
|
51国产视频
|
亚洲一区二区精品在线
|
亚洲自拍偷拍网站
|
欧美春色
|
综合激情久久
|
亚洲综合色在线
|
欧美在线专区
|
欧美色图在线播放
|
黄视频在线播放
|
欧美性生活一区二区
|
欧美第四页
|
日韩av一区二区三区在线观看
|
亚洲精品v
|
丁香六月激情
|
亚洲一区国产一区
|
四虎影库在线播放
|
欧美日韩麻豆
|
蕾丝视频污|
91久久国产综合久久91精品网站
|
亚洲国产无码精品
|
国产成人在线免费观看视频
|
欧美精品亚洲精品
|
亚洲黄色av|
黑人爱爱视频
|
日韩大片免费观看
|
欧美黑人xxxx
|
国内精品久久久久久
|
俄罗斯特级毛片
|
国产黄色片在线播放
|
好大好舒服视频
|
成人在线综合
|
狠狠操天天操
|
天天插天天射
|
欧美日韩国产高清
|
国产在线精品一区二区
|
中文有码在线
|
精品国产乱码久久久久久郑州公司
|
四虎影视库
|
奶妈的诱惑
|
性欧美sm调教
|
91热热
|
97人人爱
|
嘛豆视频|
国产一区二区中文字幕
|
亚洲熟妇色自偷自拍另类
|
亚洲精品一区二三区
|
一级黄色免费
|
午夜院线|
精品人妻午夜一区二区三区四区
|
亚洲最新中文字幕
|
欧美自拍视频
|
日韩精品免费一区二区夜夜嗨
|
国模在线观看
|
无码人妻精品一区二区三区蜜桃91
|
99热网址
|
欧美日韩精品久久久
|
永久免费视频网站直接看
|
久久一|
亚洲一区色|
中文字幕不卡在线观看
|
色av影院
|
夜夜摸夜夜操
|
夜夜操狠狠操
|
91视频在线网站
|
日本乳汁视频
|
欧美爱爱网站
|
久久久99精品免费观看
|
成人免费黄
|
午夜aaa片一区二区专区
|
久久不卡影院
|
www男人天堂
|
国产精品三|
日韩高清不卡
|
日皮视频免费观看
|
久久久久久一区二区三区
|
亚洲欧美精品一区二区三区
|
黄色精品在线观看
|
懂色av蜜臀av粉嫩av分享
|
黄免费看|
色屋在线
|
午夜免费播放观看在线视频
|
国产精品免费一区二区三区
|
久久国产亚洲
|
狠狠网站|
97精品在线观看
|
麻豆做爰免费观看
|
夜夜操夜夜爱
|
在线看一区
|
精品国产欧美一区二区三区成人
|
亚洲视频国产精品
|
国产福利在线观看
|
欧美mv日韩mv国产网站app
|
白又丰满大屁股bbbbb
|
午夜激情视频在线观看
|
亚洲高潮av
|
秘密基地动漫在线观看免费
|
亚洲成年人av
|
欧美婷婷|
www.日韩在线观看
|
野花视频免费在线观看
|
久久久久久精
|
免费在线一区二区三区
|
中文字幕观看视频
|
国语毛片
|
亚洲黄色在线观看
|
国产7777
|
久久久久噜噜噜亚洲熟女综合
|
中文字幕亚洲乱码熟女1区2区
|
日韩精品在线视频
|
男男黄网站|
色天堂视频
|
黄黄的网站
|
动漫3d精品一区二区三区乱码
|
污污内射久久一区二区欧美日韩
|
91成人在线观看喷潮动漫
|
成人国产网站
|
男人操女人网站
|
国内91视频
|
亚洲视频在线观看一区二区
|
神马久久久久久久久
|
中文字幕第一页在线
|
亚洲h视频在线观看
|
91桃色在线观看
|
国产精品高清无码在线观看
|
在线观看国产精品入口男同
|
亚洲一区二区精品在线
|
精品久久二区
|
亚洲欧美日韩综合在线
|
久久国产免费视频
|
91久久久久国产一区二区
|
冲田杏梨 在线
|
69精品国产
|
日本大乳奶做爰
|
亚洲天堂av在线播放
|
午夜欧美激情
|
伊人网免费视频
|
亚洲一区国产一区
|
日本美女一区二区
|
日日夜夜免费精品
|
美女视频在线播放
|
欧美一卡二卡三卡
|
国产一区二区av
|
国产精品一区三区
|
久久作爱视频
|
国产成人精品片
|
久久久久久少妇
|
国产三级在线观看视频
|
男人天堂一区
|
人人爱操
|
久久影院在线观看
|
欧美大片黄色
|
成人在线一区二区三区
|
国产人妻精品一区二区三区不卡
|
国产成人a人亚洲精品无码
最近中文字幕av
|
亚洲精品一二区
|
四虎在线免费观看
|
在线免费看污视频
|
不卡久久
|
日韩一级片在线
|
久久ww|
国产黄色a
|
色哟哟精品|
五月婷婷开心中文字幕
|
免费观看av的网站
|
波多野结衣av无码
|
美女视频在线播放
|
玩弄人妻少妇500系列
|
亚洲三级图片
|
超碰97人人草
|
av影视网|
天天干天天干天天干
|
国产又粗又大又硬
|
97超碰成人
|
a级免费毛片
|
天天天天天操
|
夜夜操夜夜爱
|
青青视频在线免费观看
|
性爱一级视频
|
国产成人中文字幕
|
玉女心经 在线
|
4438成人网
|
亚洲区一区二区三区
|
在线观看三级电影
|
欧美丝袜丝交足nylons
|
熟睡侵犯の奶水授乳在线
|
激情网五月
|
俄罗斯特级毛片
|
青青草国产精品
|
91久久精品日日躁夜夜躁欧美
|
国产精品乱码
|
国产午夜精品久久久
|
亚洲作爱视频
|
深夜视频18
|
欧美区一区二
|
懂色av一区二区三区免费观看
|
污污网站在线免费观看
|
久久av电影
|
中文字幕一区二区三区精华液
|
青青导航|
婷婷av一区二区三区
|
超碰狠狠操
|
国产三级在线观看视频
|
久久成人一区
|
国产成人精品无码片区在线
|
成人黄网免费观看视频
|
青青草国产精品
|
中文字幕丰满乱子伦无码专区
|
欧美日韩精品久久久
|
99久久99久久精品国产片果冻
|
蜜桃视频中文字幕
|
国内精品久久久久久
|
四虎成人精品永久免费av九九
|
国产二区电影
|
日韩脚交footjobhd
|
天天爱天天做
|
高清不卡毛片
|
欧美精品久久久久久
|
人人妻人人澡人人爽精品日本
|
午夜资源站
|
日本亚洲在线
|
中文av网
|
手机在线观看毛片
|
国产第8页
|
2019毛片
|
美女爱爱视频
|
av每日更新
|
日韩av第一页
|
亚洲日本va在线观看
|
午夜在线看
|
精品国产一
|
午夜aaa片一区二区专区
|
日韩大尺度视频
|
在线高清观看免费观看
|
国产一区二区中文字幕
|
日韩在线观看一区
|
中国一级黄色
|
一本一道久久a久久精品蜜桃
|
欧美精品亚洲精品
|
国产视频大全
|
www色日本
|
91久久国产综合久久91精品网站
|
www.国产91|
91久久国产综合久久91精品网站
|
超碰在线亚洲|
三级黄在线观看
|
国产第8页|
久久三级视频
|
韩国黄色大片
|
国产又粗又大又硬
|
精品国产欧美一区二区三区成人
|
4438全国成人免费
|
成人免费毛片男人用品
|
在线观看免费黄色
|
一区二区免费在线观看
|
92国产精品|
牛牛超碰|
色婷婷av一区二区三区之红樱桃
|
一区二区av在线
|
欧美成人免费在线视频
|
国产精品探花视频
|
精久久久久
|
www.日本高清
|
午夜免费观看视频
|
国产激情久久久久久熟女老人av
|
农村妇女毛片
|
国产成人激情
|
丰满少妇在线观看
|
97精品在线观看
|
国产第8页
|
欧美20p|
免费一级毛片麻豆精品
|
少妇av一区
|
中文字幕av久久爽一区
|
超大量吹潮系列合集
|
日韩少妇
|
欧美一卡二卡三卡
|
手机在线观看毛片
|
日本一级淫片色费放
|
精品人妻无码中文字幕18禁
|
久久精选
|
五月天av在线|
亚洲一区色|
日韩大尺度视频
|
专干老肥女人88av
|
a级黄毛片
|
欧美色妞网
|
国产成人a人亚洲精品无码
最近中文字幕av
|
97超碰成人
|
调教在线观看
|
日韩爱爱网
|
337p日本欧洲亚洲大胆张筱雨
|
av国产免费|
国产无套精品一区二区三区
|
人妻少妇精品视频一区二区三区
|
五月天狠狠干
|
人妻丰满熟妇av无码区hd
|
国产在线精品一区二区
|
欧美性生活视频
|
免费日b视频
|
国产精品久久
|
午夜激情视频在线观看
|
日本在线视频免费观看
|
亚洲九九|
欧美放荡性医生videos
|
一级片黑人
|
日本特黄一级
|
色噜噜在线观看
|
www.在线播放
|
国产免费久久
|
日韩和欧美的一区二区
|
天天干在线观看
|
美女久久久
|
欧美黑人xxxx
|
九九热九九
|
全是肉的高h文〈男男〉
|
动漫美女无遮挡免费
|
国产性色av|
在线视频 日韩
|
a天堂在线视频
|
6699嫩草久久久精品影院
|
免费三级av|
91在线观看视频
|
老司机午夜电影
|
欧美熟妇精品一区二区蜜桃视频
|
97超碰精品
|
久久午夜视频
|
ass大乳尤物肉体pics
|
国产成人a v
|
天天摸夜夜添狠狠添婷婷
|
午夜免费激情视频
|
欧美mv日韩mv国产网站app
|
伊人久久久久久久久久
|
亚洲少妇一区二区
|
两女双腿交缠激烈磨豆腐
|
四虎在线免费观看
|
亚洲精品二
|
黄黄的网站|
51国产偷自视频区视频
|
日韩欧美精品在线
|
北京富婆泄欲对白
|
深夜视频18
|
亚洲精品白浆高清久久久久久
|
中国女人内谢69xxxx
|
欧美高清免费
|
免费观看av的网站
|
免费精品久久
|
中文字幕亚洲精品
|
久久一二三四区
|
污视频网站在线看
|
国产在线精品一区二区
|
视频在线你懂的
|
午夜精品久久久久久久久久
|
51国产偷自视频区视频
|
亚洲精品中文字幕
|
亚洲免费中文字幕
|
亚洲综合久久久
|
午夜精品电影
|
天堂av在线资源
|
奇米久久
|
少妇高潮惨叫久久久久久
|
完美搭档在线观看
|
风流少妇一区二区三区91
|
欧美a∨
|
插入综合网
|
西西人体大胆4444www
|
啪啪网站免费看
|
秋霞av鲁丝片一区二区
|
五月开心网
|
911精品国产一区二区在线
|
少妇av一区
|
香港a毛片
|
亚洲涩综合
|
欧美成人精品激情在线视频
|
成人国产网站
|
亚洲美女一区二区三区
|
黑人极品ⅴideos精品欧美棵
|
黑丝啪啪
|
久久成年人视频
|
黑人性高潮
|
激情小说在线
|
潘金莲一级淫片免费放动漫
|
www.一区二区
|
在线播放国产一区
|
国产在线高清
|
超碰美女
|
91桃色在线观看
|
最新国产露脸在线观看
|
午夜精品一区二区三区在线视频
|
80日本xxxxxxxxx96
国产超级av
|
欧美性视屏
|
米奇影视777
|
中文字幕在线免费看
|
成人av专区|
天天摸夜夜添狠狠添婷婷
|
成人动漫网站在线观看
|
男人天堂一区
|
强行糟蹋人妻hd中文
|
人人爱操
|
国内视频精品
|
性高潮久久久久久久
|
日本久久99
|
xxx在线视频
|
一级免费黄色片
|
在线观看国产精品入口男同
|
亚洲熟妇色自偷自拍另类
|
强睡邻居人妻中文字幕
|
天天操天天插天天射
|
国产精品久久网站
|
国产无遮挡裸体免费视频
|
国产乱乱|
亚洲作爱视频
|
在线观看亚洲
|
精久久久久
|
色妞综合|
欧美日韩在线观看一区二区
|
成人av图片
|
国产精品天天狠天天看
|
www.一区二区
|
前所未有的深入
|
av国产免费
|
精品无码国产一区二区三区51安
|
精品美女一区二区三区
|
日韩美女网
|
青青草国产成人99久久
|
亚洲青青草原
|
456亚洲影院
|
日韩精品免费一区二区夜夜嗨
|
永久免费在线
|
美女扒开双腿
|
91黄色免费视频
|
国产伦精品一区
|
黄色网址免费
|
精品人妻午夜一区二区三区四区
|
1024国产在线
|
亚洲黄色小说网
|
青娱乐青青草
|
超碰青青操|
看黄色一级视频
|
gogogo日本免费观看电视
|
精品人妻无码中文字幕18禁
|
日本少妇xxxx软件
|
久热最新
|
淫视频在线观看
|
欧美综合激情网
|
91桃色在线观看
|
久久影片|
免费一级大片
|
强睡邻居人妻中文字幕
|
久久99久久99精品免观看软件
|
熟妇高潮一区二区三区
|
久久综合社区
|
国产精品1024
|
亚洲精品乱码久久久久
|
亚洲精品色午夜无码专区日韩
|
污片视频在线观看
|
玖玖玖影院
|
女人做爰全过程免费观看美女
|
依人久久
|
日韩啊啊啊
|
国偷自产视频一区二区久
|
无码人妻久久一区二区三区
|
精品国产乱码久久久久久郑州公司
|
美国免费高清电影在线观看
|
99久久99久久精品国产片果冻
|
欧美片网站免费
|
99久久99久久精品国产片果冻
|
黄免费看
|
国产又粗又猛视频免费
|
亚洲国产精品无码久久久久高潮
|
丁香花电影免费播放电影
|
久久成人免费视频
|
另类日韩
|
国产精品久久久久久亚洲色
|
国产片91|
久久99久久99精品免观看软件
|
黄色网址免费
|
插插影视|
日韩人妻无码一区二区三区99
|
在线观看国产精品入口男同
|
国产精品sm|
欧美资源在线
|
欧美mv日韩mv国产网站app
|
草比网站
|
黄污视频在线观看
|
色综合中文字幕
|
强睡邻居人妻中文字幕
|
a级片免费在线观看
|
国产夜夜操
|
青娱乐超碰在线
|
欧美xxxx18国产|
少妇一级片
|
国产成人激情
|
爱草在线视频
|
五月天婷婷综合网
|
四虎影视免费永久大全
|
三级av在线
|
好吊一区二区三区
|
欧美一级网|
成人xx视频
|
国产三级在线观看视频
|
中文字字幕在线中文乱码电影
|
国产精品久久久久久吹潮
|
少妇扒开粉嫩小泬视频
|
成人黄页|
天天躁日日躁aaaaxxxx
|
精品美女一区二区三区
|
国产97在线观看
|
日韩av无码一区二区三区
|
99re国产精品
|
精品久久网
|
熟妇高潮一区二区三区
|
欧美精品 在线观看
|
中文字幕8
|
特黄色一级片
|
免费看日韩毛片
|
95在线视频
|
在线不卡
|
熟睡侵犯の奶水授乳在线
|
国产免费不卡
|
免费成人av片
|
成年人免费网站在线观看
|
波多在线观看
|
青娱乐超碰在线
|
开心激情播播
|
张柏芝亚洲一区二区三区
|
日韩av无码一区二区三区
|
一起操在线观看
|
91免费视频|
欧美激情自拍偷拍
|
色噜噜在线观看
|
暖暖日本在线视频
|
激情小说亚洲图片
|
www夜片内射视频日韩精品成人
|
欧美夜夜
|
今天高清视频在线观看播放
|
一级片手机在线观看
|
中文字幕丰满乱子伦无码专区
|
色哟哟精品
|
国产亚洲精品成人a
|
欧美性生活一区二区
|
久久久国产一区二区三区
|
巨粗高h双龙筋肉体育生
|
黄色1级视频
|
欧美日韩麻豆
|
91抖音在线观看
|
天天干在线观看
|
特黄aaaaaaaaa真人毛片
|
少妇69xx|
手机在线观看毛片
|
青青91
|
久草99|
2019中文字幕在线观看
|
国产视频资源
|
日本精品一区二区三区视频
|
日韩2区|
激情五月婷婷
|
欧美私人影院
|
亚洲免费观看高清
|
国产美女视频免费观看下载软件
|
禁断介护老人中文字幕
|
小嫩女直喷白浆
|
yy6080午夜|
一本不卡|
欧美国产片
|
老师让我她我爽了好久视频
|
久久国产小视频
|
日本久久久久久久久久
|
国产视频一区在线
|
激情宗合网
|
一区二区三区日本
|
天天摸夜夜添狠狠添婷婷
|
天堂av在线资源
|
久久综合社区
|
麻豆做爰免费观看
|
9.1人网站|
亚洲黄色在线观看
|
欧洲成人av
|
日本少妇色
|
久色网站
|
国产第页
|
99精品视频在线
|
精品无码久久久久
|
在线高清观看免费
|
欧美色图狠狠干
|
国产视频资源
|
国产亚洲一区二区三区在线观看
|
欧美四区
|
91热热
|
天天操天天插天天射
|
久久久观看
|
蜜桃视频中文字幕
|
毛片三级
|
欧美激情性做爰免费视频
|
在线无限看免费粉色视频
|
国产精品xxx在线观看
|
日本黄色xxx|
国产黄色片在线播放
|
久久久99精品免费观看
|
欧美资源在线
|
中文字幕av久久爽一区
|
性生活视屏
|
成人黄色免费电影
|
大地资源二中文在线影视观看
|
欧美午夜精品一区二区
|
在线观看www.
|
在线精品观看
|
久久作爱视频
|
中文字幕av久久爽一区
|
国产又粗又大又爽视频
|
亚洲国产精品免费
|
国产精品视频在线观看
|
欧美精品亚洲精品
|
日本一区二区视频在线
|
熟妇熟女乱妇乱女网站
|
国产第页
|
午夜aaa片一区二区专区
|
ass大乳尤物肉体pics
|
久久精品爱
|
亚洲天堂第一页
|
国产人成视频在线观看
|
色哟哟精品|
国产人妻精品一区二区三区不卡
|
国产片91|
国产成人a人亚洲精品无码
最近中文字幕av
|
超碰在线免费公开
|
国精品一区
|
99在线视频精品
|
国产又粗又猛视频免费
|
亚洲女成人图区
|
中文字幕综合在线
|
国产精品白丝喷水在线观看
|
国产午夜在线视频
|
亚洲手机在线观看
|
大地二资源在线观看高清国语版
|
日韩黄色免费观看
|
国产精品呻吟
|
久色网站
|
少妇无码一区二区三区
|
性生活免费网站
|
麻豆av一区二区
|
自拍偷拍国产精品
|
星铁乱淫h侵犯h文
|
免费一二三区
|
性色av蜜臀av浪潮av老女人
|
国产精品免费一区二区三区
|
性视频免费
|
欧美性视屏|
九九热九九
|
色欲av无码一区二区三区
|
色哟哟精品一区
|
篠田优在线
|
黄色小说免费在线观看
|
国产18在线
|
嘛豆视频
|
黄色片链接
|
欧美激情性做爰免费视频
|
天天摸天天爽
|
一级黄色免费
|
淫欲的美女理论电影完整版
|
精品久久二区
|
亚洲国产精品无码久久久久高潮
|
午夜av网站|
国产精品久久一区二区三区
|
免费在线一区二区三区
|
mm131美女视频
|
aaaa一级片
|
欧美zzoo|
青青草日本
|
成人影片在线播放
|
中文字幕丰满乱子伦无码专区
|
亚洲国产精品免费
|
久久久久免费观看
|
色蝌蚪|
五月丁香久久婷婷
|
天堂国产
|
91久久久久久
|
亚洲第一男人天堂
|
久久亚洲精品小早川怜子
|
久久av一区|
婷婷av一区二区三区
|
日韩av一二三
|
高h言情|
精品无码国产一区二区三区51安
|
日本性视频网站
|
日韩精品免费一区二区夜夜嗨
|
小早川怜子一区二区三区
|
男女网站免费
|
av老女人
|
免费日b视频|
国产无套精品一区二区三区
|
色愁久久
|
国产亚洲一区二区三区在线观看
|
国产又粗又大又爽视频
|
日本久色|
国产午夜在线视频
|
少妇扒开粉嫩小泬视频
|
日韩一区二区三区四区五区六区
|
想要视频在线观看
|
火影忍者羞羞漫画
|
亚洲国产精品免费
|
亚洲xxx视频
|
亚洲精品色午夜无码专区日韩
|
免费网站观看www在线观
|
久久成人免费视频
|
日韩精品一区在线观看
|
婷婷综合五月
|
人人草人人爽
|
玩弄人妻少妇500系列
|
人人草在线|
精品无码久久久久久久久
|
在线高清观看免费
|
卡一卡二卡三
|
日日干日日插
|
免费观看毛片视频
|
亚洲成人精品久久
|
高h喷水荡肉少妇爽多p视频
|
国产三级在线观看视频
|
日本免费中文字幕
|
欧美日韩三级在线
|
麻豆精品一区二区
|
中国国产bdsm紧缚捆绑
|
亚洲色图另类
|
精品午夜福利视频
|
中文字幕一区二区三区5566
|
91精品国产综合久久香蕉922
|
国产亚洲一区二区三区在线观看
|
亚洲三级精品
|
日本特黄一级
|
久久99视频
|
欧洲成人av|
国产精品欧美在线
|
久草高清视频
|
成人免费视频国产免费
|
妻子的性幻想
|
91丝袜在线
|
99久久99久久精品国产片果冻
|
97人妻精品一区二区三区免
|
看全色黄大色黄女片18
|
九九综合网
|
久久成人在线
|
久久成年人视频
|
久久久久久久精
|
mm131美女视频
|
女人做爰全过程免费观看美女
|
av在线播放中文字幕
|
久久久国产一区二区三区
|
综合久久久久
|
潘金莲一级淫片免费放动漫
|
女女les互磨高潮国产精品
|
色吧av色av|
v天堂在线观看
|
欧美做受xxxxxⅹ性视频
|
视频在线你懂的
|
欧美夜夜
|
国产在线精品一区二区
|
成人免费毛片果冻
|
天天干夜夜欢
|
欧美尻逼
|
亚洲理论片
|
五月婷婷六月色
|
草民午夜理伦三级
|
免费成人av在线
|
欧美一区二区三区不卡
|
亚洲美女一区二区三区
|
天天摸夜夜添狠狠添婷婷
|
中文字幕一二三
|
神马影院午夜伦理
|
欧美交换国产一区内射
|
激情开心成人网
|
五月婷婷激情四射
|
国产成人av一区
|
一区二区三区欧美视频
|
亚洲第一男人天堂
|
一本一道久久a久久精品蜜桃
|
日本高清三区
|
猫咪av在线
|
国产精品精品国产
|
91免费大片|
日韩和欧美的一区二区
|
亚洲免费资源
|
日韩国产欧美一区二区
|
欧美69久成人做爰视频
|
人成在线|
国产性色av|
欧美午夜在线
|
精品欧美在线
|
国产精品天天狠天天看
|
亚洲av无码国产综合专区
|
人妻精品久久久久中文字幕
|
国产午夜电影
|
欧美午夜精品一区二区
|
久久久久久久久久网站
|
无码人妻精品一区二区三区蜜桃91
|
国产色播
|
男人的天堂一区二区
|
91桃色在线观看
|
天天摸夜夜添狠狠添婷婷
|
亚洲日本中文
|
三浦理惠子av在线播放
|
夜色资源网
|
久久综合99
|
蜜桃91视频
|
青春草视频
|
91亚洲精品在线观看
|
亚洲综合一区二区三区
|
一区二区免费
|
日韩精品久久久久久久
|
中国国产bdsm紧缚捆绑
|
96视频在线
|
福利视频一区
|
欧美日韩亚洲二区
|
日皮视频免费观看
|
天天操天天操天天操
|
亚洲欧洲日本在线
|
综合激情久久
|
久久久久免费观看
|
99热这里只有精品在线观看
|
中文字幕一区二区三区精华液
|
毛茸茸的中国女bbw
国产午夜精品久久久
|
熟女人妻aⅴ一区二区三区60路
|
永久91嫩草亚洲精品人人
|
精品美女一区二区三区
|
丰满熟妇被猛烈进入高清片
|
永久免费在线
|
一本不卡
|
91老肥熟|
乱日视频|
伊人天堂av|
免费黄色网址大全
|
日本少妇xxxx软件
|
国精品一区
|
亚洲视频国产精品
|
看全色黄大色黄女片18
|
操干视频
|
人人爱操|
波多野结衣中文字幕在线
|
日日夜夜精
|
色婷婷国产精品
|
亚洲专区在线播放
|
欧美在线免费观看视频
|
日韩人妻无码一区二区三区99
|
国产精品免费一区二区三区
|
不良视频在线观看
|
欧美专区第一页
|
欧美成人高清视频
|
超碰97人人爱
|
国产黄色a
|
做爰视频
|
日本黄色精品
|
污视频网站在线看
|
激情五月婷婷
|
国产黄色高清视频
|
91大尺度
|
欧k影视|
亚洲欧美另类图片
|
91麻豆精品一二三区在线
|
欧美亚洲另类小说
|
三上悠亚 在线观看
|
亚洲高潮av
|
蜜桃成人网|
好吊操视频这里只有精品
|
人人综合
|
亚洲视频国产精品
|
成人啪啪漫画羞羞漫画
|
日本一级一片免费视频
|
国语毛片
|
好大好舒服视频
|
香蕉视频久久
|
最新日韩在线
|
色噜噜狠狠狠综合曰曰曰
|
婷婷亚洲天堂
|
91手机在线
|
日屁网站
|
中文字幕观看视频
|
午夜av网站
|
操大爷影院
|
国产美女自慰在线观看
|
欧美熟妇精品一区二区蜜桃视频
|
国精品一区
|
自拍偷拍第五页
|
娇小的粉嫩xxx极品
天天射天天射
|
亚洲高潮av
|
极度诱惑香港电影完整
|
久久精品国产亚洲AV无码男同
|
精品国产欧美一区二区三区成人
|
色吧av色av|
丁香婷婷久久久综合精品国产
|
老师让我她我爽了好久视频
|
日韩在线免费av
|
欧美激情黑白配
|
国产精品自拍偷拍
|
亚洲欧美精品一区二区三区
|
波多野结衣简介
|
亚洲欧美精品一区二区三区
|
国产精品视频在线观看
|
婷婷欧美
|
欧美脚交
|
柠檬福利第一导航在线
|
男人操女人的视频
|
爱爱色图|
天堂影视在线观看
|
在线观看网页视频
|
成年人视频网站
|
福利电影网|
九九视频在线播放
|
亚洲免费中文字幕
|
女~淫辱の触手3d动漫
|
91大尺度|
久草五月天
|
97精产国品一二三产区
|
欧美又粗又深又猛又爽啪啪九色
|
亚洲精品777
|
专干老肥女人88av
|
人人澡人人看
|
色哟哟精品
|
操操干干
|
嘛豆视频
|
狠狠网站
|
一区二区三区日本
|
国产乱乱
|
午夜大片|
香蕉视频久久
|
日本中文字幕一区
|
中文字幕一区二
|
欧美亚洲国产一区二区三区
|
污片视频在线观看
|
俄罗斯厕所偷拍
|
91丝袜在线
|
色人阁视频
|
午夜肉体高潮免费毛片
|
国产成人在线观看免费网站
|
国产精品第三页
|
高清不卡毛片
|
久久极品视频
|
成人av图片
|
人妻精品久久久久中文字幕
|
99资源在线
|
国产成人毛片
|
久久久精品免费观看
|
欧美亚洲在线视频
|
中文有码在线
|
国产午夜精品久久久
|
欧美第四页
|
亚洲最新网址
|
污污视频免费观看
|
久久亚洲精品小早川怜子
|
少妇高潮惨叫久久久久久
|
高清不卡毛片
|
欧美激情一区二区三区
|
超碰97人人草
|
爱综合网
|
日本精品视频在线播放
|
日本精品视频在线播放
|
波多野结衣人妻
|
又粗又大又深又硬又爽
|
都市激情一区
|
日本伊人久久
|
精品久久免费
|
欧美综合激情网
|
永久91嫩草亚洲精品人人
|
欧美a∨|
国产高清免费在线播放
|
午夜免费播放观看在线视频
|
色久视频
|
日本人体视频
|
亚洲专区在线播放
|
秋霞av鲁丝片一区二区
|
手机在线免费看av
|
天天躁日日躁aaaaxxxx
|
久久影片|
国产在线无码精品
|
欧美综合一区二区三区
|
美女一区二区三区四区
|
动漫3d精品一区二区三区乱码
|
日韩精品久久久久久久
|
国产成人a人亚洲精品无码
最近中文字幕av
|
北条麻妃99精品青青久久
|
大香焦久久
|
国产免费久久
|
国产在线精品视频
|
无码人妻精品一区二区三区蜜桃91
|
日本伊人久久
|
国产黄色高清视频
|
爱情岛亚洲论坛入口福利
|
久章草影院|
大陆熟妇丰满多毛xxxⅹ
|
99婷婷
|
国产青青草视频
|
日本国产一区二区三区
|
国产一区二区欧美
|
av在线免费电影
|
欧美老熟妇xb水多毛多
|
久草五月天
|
人人澡人人看
|
中日一级片
|
黄污视频在线观看
|
国产精品天天狠天天看
|
看全色黄大色黄女片18
|
大地二资源在线观看高清国语版
|
最新国产露脸在线观看
|
久久精品一
|
久久精品国产亚洲AV无码男同
|
亚洲国产成人精品女人久久久
|
久草色在线
|
免费看黄色a级片
|
在线不卡一区
|
av在线电影网
|
一级大片视频
|
91狠狠|
午夜a级片
|
久久大香
|
日本伊人久久
|
久久久国产一区二区三区
|
91精品国产91久久久久久黑人
|
91精品国产aⅴ一区二区
|
爱爱色图
|
国产精品乱码
|
av视屏|
久草视频免费在线
|
欧美激情第五页
|
欧美20p
|
日本少妇色|
av蜜臀网站|
成年人视频网
|
久久作爱视频
|
日韩免费网站
|
两女双腿交缠激烈磨豆腐
|
国产又粗又大又爽视频
|
91好色先生|
97自拍偷拍
|
中文字幕亚洲乱码熟女1区2区
|
四虎在线免费观看
|
国产白丝在线观看
|
午夜不卡av免费
|
久久久久免费观看
|
gogo人体做爰大胆视频
|
亚洲三级图片
|
麻豆做爰免费观看
|
高清日韩
|
少妇69xx|
日韩一区二区三区四区在线
|
巨粗高h双龙筋肉体育生
|
成人免费视频国产免费
|
国产美女视频免费观看下载软件
|
久久大香
|
成人午夜淫片免费观看
|
玖玖玖影院
|
日韩精品无码一区二区三区久久久
|
51 吃瓜网|
亚洲在线电影
|
久久综合社区
|
色视屏
|
久久综合社区
|
在线看一级片
|
天天操天
|
91狠狠|
蜜乳av红桃嫩久久
|
国产精品111
|
中文在线免费视频
|
奇米影视在线播放
|
成人av电影免费观看
|
污视频网站在线看
|
男女涩涩
|
亚洲精品乱码久久久久
|
国产青青青
|
中文字幕第一页在线
|
日韩精品无码一区二区三区久久久
|
成人丁香婷婷
|
色七七视频
|
绿帽视频
|
人成在线
|
中文字幕一区二
|
日韩av一区在线
|
丰满大爆乳波霸奶
|
日日操夜夜爱
|
91视频在线网站
|
亚洲一区在线视频观看
|
国产传媒一区
|
亚洲欧洲日本在线
|
深夜成人福利视频
|
天天综合影院
|
日本五十肥熟交尾
|
国产日韩电影
|
亚洲一区在线视频观看
|
日韩欧美大片在线观看
|
久久一二三四区
|
无码人妻精品一区二区三区蜜桃91
|
你懂得在线观看
|
天天狠狠操
|
久久精选|
日日骚影院
|
极度诱惑香港电影完整
|
日本精品一区二区三区视频
|
欧美精品videos另类
|
www夜片内射视频日韩精品成人
|
亚洲女成人图区
|
97精产国品一二三产区
|
黄色h视频
|
日韩一区二
|
爱逼综合
|
人人综合
|
日本极品丰满ⅹxxxhd
|
农村老妇性真猛
|
日本高清视频在线
|
国产亚洲精品女人久久久久久
|
91好色先生|
午夜免费在线
|
国产精品999
|
在线精品观看
|
成人黄色免费电影
|
夜夜操夜夜爱
|
av大片在线|
91片看|
日韩久久一区二区
|
亚洲免费观看高清
|
精品九九九九
|
性综艺节目av在线播放
|
国产福利在线观看
|
北条麻妃av在线
|
日本少妇色
|
色戒未删节版
|
特级毛片在线观看
|
福利视频免费
|
91抖音在线观看
|
国产在线精品一区二区
|
激情视频一区
|
www午夜|
国产精品视频入口
|
久久国产精品偷
|
日韩免费|
午夜免费观看视频
|
日本伊人久久
|
视频在线观看免费大片
|
女~淫辱の触手3d动漫
|
女m被s玩胸虐乳哭着求饶
|
日本一级淫片色费放
|
97精品在线观看
|
91久久国产
|
日本在线视频免费观看
|
成人久久视频
|
欧美伦乱
|
天堂国产|
三级黄在线观看
|
在线欧美
|
久久久精品免费观看
|
玩弄人妻少妇500系列
|
99激情|
日韩在线观看一区
|
一级大片视频
|
日韩影音
|
亚洲免费福利视频
|
欧美黄色片免费看
|
午夜国产片
|
精品无码久久久久久久久
|
免费a视频在线观看
|
白又丰满大屁股bbbbb
|
午夜免费在线
|
国产a级黄色片
|
成人影片在线播放
|
欧美性生活一区二区
|
日本乳汁视频
|
美女扒开尿口给男人桶
|
欧美熟妇精品一区二区蜜桃视频
|
人妖一区|
久久综合狠狠综合久久综合88
|
欧美脚交|
91午夜影院|
蕾丝视频污
|
1024国产精品
|
火影忍者羞羞漫画
|
成人啪啪漫画羞羞漫画
|
在线高清观看免费观看
|
蜜桃av噜噜一区二区三区麻豆
|
欧美成人免费在线视频
|
欧美激情自拍偷拍
|
欧美性生活一区二区
|
www.在线播放|
超碰97人人草
|
国产亚洲色婷婷久久
|
欧美国产日韩一区
|
不卡在线播放
|
特黄aaaaaaaaa毛片免费视频
|
日韩精品在线一区
|
一级黄色大片
|
人妻丰满熟妇av无码区hd
|
97精产国品一二三产区
|
在线观看国产黄色
|
成人在线综合
|
日本欧美激情
|
国产免费久久
|
亚洲色图另类
|
日韩av一区二区三区在线观看
|
国产乱码精品一区二区三区中文
|
日一日射一射
|
日本黄色xxx
|
免费看日韩毛片
|
18免费网站
|
操操干干
|
欧美性猛交xxxx乱大交退制版
|
人人草在线
|
av在线播放网站
|
午夜av网站
|
婷婷中文|
www.五月激情
|
中文有码在线
|
亚洲免费资源
|
日韩精品视频在线免费观看
|
玉女心经 在线
|
丰满大爆乳波霸奶
|
男人操女人的视频
|
久久久91|
在线观看www.
|
国产精品自拍一区
|
www.午夜视频|
婷婷香蕉
|
色视频网
|
麻豆视频免费版
|
午夜三区|
在线观看三级电影
|
欧美a∨
|
亚洲午夜精品一区二区三区
|
人妻少妇精品视频一区二区三区
|
久热只有精品
|
成年人精品
|
免费在线观看黄色av
|
久久亚洲一区二区
|
午夜a级片|
久草久热
|
色中色在线视频
|
成人激情片
|
9999在线视频
|
色蝌蚪|
免费看日韩毛片
|
极度诱惑香港电影完整
|
国产亚洲色婷婷久久99精品91
|
国产黄色a
|
四虎在线免费观看
|
日韩精品久
|
欧美日韩专区
|
国产精品呻吟
|
国产成人a v
|
欧美一级网
|
91免费短视频
|
欧美性猛交xxxx乱大交俱乐部
|
在线观看毛片网站
|
日韩午夜精品
|
今天高清视频在线观看播放
|
就去吻亚洲|
91欧美精品|
国产一区二区在线免费
|
日韩成人一区二区
|
婷婷av一区二区三区
|
久草网在线视频
|
国产日b视频
|
国产无套精品一区二区三区
|
特级毛片在线观看
|
男女网站免费
|
午夜大片
|
日本中文字幕一区
|
黄污网
|
69精品国产
|
91精品网|
天天干夜夜欢
|
娇小的粉嫩xxx极品
天天射天天射
|
少妇被躁爽到高潮无码人狍大战
|
传媒av在线
|
欧美一区二区视频在线
|
久久久久久中文字幕
|
午夜久久福利
|
97人人爱|
色婷婷伊人
|
久草网在线视频
|
碧蓝之海动漫在线观看免费高清
|
欧日韩一区二区三区
|
就去吻亚洲
|
91精品国产aⅴ一区二区
|
一区二区三区欧美视频
|
国产成人在线免费观看视频
|
午夜在线观看视频
|
涩涩五月天|
四虎成人精品永久免费av九九
|
色哟哟精品
|
久章草影院
|
国产成人高清在线
|
91抖音在线观看
|
亚色中文
|
久久一|
亚洲综合区
|
日日夜夜免费精品
|
香蕉视频免费看
|
奶妈的诱惑|
三级av电影|
99婷婷
|
一区二区免费在线观看
|
狠狠干2023|
久久久久极品
|
91香蕉视频黄色
|
色图一区|
久久超
|
aaa亚洲精品
|
很黄很污的网站
|
黄黄的网站
|
人妻少妇精品视频一区二区三区
|
成人91视频
|
av国产免费|
午夜免费在线
|
中文天堂网|
一级大片视频
|
欧美激情黑白配
|
国产精品xxx在线观看
|
西西人体大胆4444www
|
亚洲成年人
|
中文字字幕在线中文乱码电影
|
在线观看国产精品入口男同
|
婷婷综合五月
|
99爱在线|
91嫩草在线
|
日韩av一区在线
|
久久99久久99精品免观看软件
|
午夜在线观看影院
|
久操福利视频
|
午夜免费观看视频
|
成年人性生活视频
|
欧美亚洲中文精品字幕
|
欧美国产日韩一区
|
亚洲涩综合
|
久久免费在线视频
|
国产7777
|
激情小说亚洲图片
|
av电影免费在线播放
|
日韩精品福利
|
一级黄色免费
|
欧美日韩性视频
|
午夜美女福利
|
一区二区三区欧美视频
|
三级av片|
精品1区2区3区
|
www.久久|
婷婷五月综合久久中文字幕
|
久久在线看
|
污视频网站在线看
|
国产精品久久久久久吹潮
|
色鬼艳魔大战1春荡女淫
|
成人自拍av
|
性高潮视频在线观看
|
日本精品在线播放
|
国产在线精品一区二区
|
日韩电影院
|
老司机午夜电影
|
91欧美精品
|
中文字幕不卡在线观看
|
性视频播放免费视频
|
欧美性生活一区二区
|
视频网站在线观看18
|
欧美在线免费观看视频
|
香蕉视频黄色
|
国产成人精品片
|
欧美激情一区二区三区
|
精品无码人妻一区二区三区品
|
久久免费看少妇高潮
|
永久免费在线
|
动漫美女无遮挡免费
|
欧美性猛交xxxx乱大交退制版
|
欧美亚洲国产日韩
|
国产91在线视频
|
久久久久性|
岛国av大片
|
性生活免费网站
|
国产无套精品一区二区三区
|
国产伦精品一区
|
超碰青青操
|
成人教育av|
40到50岁中老年妇女毛片
|
日韩一区二
|
亚洲国产精品无码久久久久高潮
|
国产色网站
|
国产一区二区视频在线
|
男人天堂一区
|
波多野结衣简介
|
在线观看国产精品入口男同
|
www.久久|
欧美黑人xxxx
|
99热日韩|
国产精品三
|
精品无码人妻一区二区三区品
|
一起操在线观看
|
打白嫩光屁屁女网站
|
亚洲精品中文字幕
|
成年人毛片
|
成人观看|
国产在线看片
|
日本国产一区
|
亚洲深夜视频
|
亚洲av无码乱码国产精品久久
|
a级片免费在线观看
|
午夜美女福利
|
亚洲免费三级
|
国产第8页
|
天天天天干
|
好大好舒服视频
|
韩国无码一区二区三区精品
|
91成人在线观看喷潮动漫
|
国产精品111
|
久久精品9
|
中文字幕视频在线观看
|
成人黄色录像
|
成年人视频免费在线观看
|
天天干夜夜欢
|
可以免费看的av网站
|
黑人极品ⅴideos精品欧美棵
|
亚洲欧洲视频
|
国产视频一区二区在线观看
|
黄色片网站在线观看
|
人人草在线
|
俄罗斯特级毛片
|
秋霞午夜|
99久久久无码国产精品免费蜜柚
|
日韩三级黄色
|
成人h在线观看
|
午夜不卡av免费
|
日本在线观看
|
色婷婷小说
|
a级黄毛片|
国产精品自拍偷拍
|
好看的h文
|
欧美成人小视频
|
大地资源二中文在线影视观看
|
欧美9999
|
欧美9999|
色久视频
|
天天操天|
国产亚洲一区二区三区在线观看
|
久久成年人视频
|
禁断介护老人中文字幕
|
7777奇米影视
|
免费在线一区二区三区
|
精品国产乱码久久久久久郑州公司
|
久久国产精品免费视频
|
国产精品入口麻豆
|
日韩av一区二区三区在线观看
|
视频一区在线播放
|
日本一区二区在线
|
国产夜夜操
|
污视频网站在线看
|
日韩久久一区二区
|
日本久久99
|
可以免费看的av网站
|
中文字幕第12页
|
日韩av无码一区二区三区
|
成人影片在线播放
|
一级做a视频
|
欧美片网站免费
|
操操干干
|
性生活免费网站
|
九九九九精品九九九九
|
日本精品视频在线播放
|
免费看日韩毛片
|
国产精品探花一区二区在线观看
|
欧美日韩一区二区三
|
久久成人一区
|
免费一级毛片麻豆精品
|
人人妻人人澡人人爽精品日本
|
午夜av免费看
|
一区二区免费在线观看
|
亚洲欧美在线看
|
国产精品视频在线观看
|
老师让我她我爽了好久视频
|
日本在线视频中文字幕
|
丁香六月综合
|
亚洲国产精品无码久久久久高潮
|
色综合中文字幕
|
成人看片泡妞
|
久久精品一
|
麻豆成人在线
|
99re国产精品
|
一区二区三区日本
|
午夜黄色小视频
|
少妇无码一区二区三区
|
日韩精品久久久久久久
|
波多野吉衣一二三区乱码
|
国产亚洲精品成人a
|
日韩一页
|
亚洲特级毛片
|
国产乱码一区
|
日本少妇xxxx软件
|
激情视频一区
|
火影忍者羞羞漫画
|
中文在线免费视频
|
草民午夜理伦三级
|
淫欲的美女理论电影完整版
|
国产性色av
|
亚洲国产成人精品女人久久久
|
av中文天堂|
亚洲欧洲视频
|
亚洲综合中文字幕在线
|
亚洲熟妇无码久久精品
|
欧美又粗又大aaa片
亚洲欧洲视频
|
日日骚影院
|
福利视频一区
|
欧美专区第一页
|
色婷婷小说
|
99re国产精品
|
插插影视|
中文字幕自拍偷拍
|
亚洲欧美日本一区
|
野花视频免费在线观看
|
人妻精品久久久久中文
|
灌篮高手全国大赛电影
|
欧美成人激情在线
|
无码人妻aⅴ一区二区三区玉蒲团
|
中文字幕综合在线
|
橹图极品美女无圣光
|
gogo人体做爰大胆视频
|
久久影院在线观看
|
国产精品入口麻豆
|
欧美激情黑白配
|
丰满的女邻居
|
a一级黄色|
日韩精品免费一区二区夜夜嗨
|
人妻少妇精品视频一区二区三区
|
国产精品免费一区二区三区
|
亚洲国产成人精品女人久久久
|
琪琪五月天
|
亚洲天堂第一页
|
前所未有的深入
|
性生活免费网站
|
国产在线97|
操操干干|
激情开心网站
|
午夜aaa片一区二区专区
|
少妇久久久久
|
国产呦系列
|
一级免费黄色片
|
中文在线www
|
亚洲青青草原
|
午夜精品一区二区三区在线视频
|
超碰免费av
|
欧亚一区二区
|
毛片三级
|
手机在线免费看av
|
综合激情久久
|
欧k影视|
灌篮高手全国大赛电影
|
www.香蕉|
成人片免费视频
|
岛国av大片|
在线观看xxxx
|
高清久久久
|
免费一级片视频
|
老司机午夜电影
|
成人在线一区二区三区
|
日本女v片|
欧美bbbbbbbbbbbb精品
|
久久影院在线观看
|
亚洲不卡在线视频
|
久久久久9999
|
aaa亚洲精品
|
好看的h文
|
国产青青青
|
91精品国产aⅴ一区二区
|
亚洲视频二
|
色戒未删节版
|
在线无限看免费粉色视频
|
一级黄色大片
|
鲁一鲁在线
|
91精品国产综合久久久蜜臀粉嫩
|
激情小说亚洲图片
|
午夜院线
|
草莓视频污视频
|
特色黄色片
|
久久成人免费视频
|
1769在线视频
|
日韩精品视频在线免费观看
|
污视频网站在线看
|
久久久久久国产精品
|
国产在线精品视频
|
欧美第一页
|
国产午夜电影
|
涩涩97
|
911精品国产一区二区在线
|
色综合网址
|
免费av影视
|
国产精品视频在线观看
|
色婷婷av一区二区三区之红樱桃
|
安装下载app|
野花视频免费在线观看
|
爱爱色图|
国产色播
|
在线观看www.
|
国产日韩电影
|
超碰麻豆|
国产一极片
|
自拍亚洲欧美
|
色蝌蚪|
国产又粗又大又爽视频
|
欧美爱爱网站
|
欧美丝袜丝交足nylons
|
97精产国品一二三产区
|
狠狠香蕉
|
91成人在线观看喷潮动漫
|
国产又粗又猛又爽又黄的
|
日本精品视频在线播放
|
天天插天天射
|
在线看福利影
|
日本美女一区二区
|
欧美一级爱爱
|
亚洲天堂日本
|
奇米影视在线播放
|
国产成人在线免费观看视频
|
日韩av无码一区二区三区
|
国产精品探花一区二区在线观看
|
综合激情久久
|
国产97视频
|
国产精品电影网站
|
男人的天堂一区二区
|
日韩城人网站
|
久久亚洲电影
|
全是肉的高h文〈男男〉
|
97在线公开视频
|
午夜精品久久久久久久爽
|
337p日本欧洲亚洲大胆张筱雨
|
成人啪啪漫画羞羞漫画
|
亚洲精品自拍
|
国产三级在线观看视频
|
日韩视频一区在线观看
|
高清不卡毛片
|
91成人免费视频
|
亚洲啊v
|
性爱一级视频
|
精品不卡视频
|
免费在线观看黄色av
|
日本特黄一级
|
视频一区在线播放
|
熟妇熟女乱妇乱女网站
|
成人免费视频国产免费
|
人人爱操
|
丰满少妇在线观看
|
日韩精品免费一区二区夜夜嗨
|
国产三级久久
|
亚洲第一免费
|
亚洲爽爽|
日本一区二区在线
|
黄漫app
|
大陆熟妇丰满多毛xxxⅹ
|
九九视屏
|
久久国产亚洲
|
欧美在线亚洲
|
一区二区在线免费观看视频
|
免费看欧美大片
|
成年网站在线视频网站
|
亚洲精品色午夜无码专区日韩
|
www男人天堂
|
在线不卡
|
欧美成人精品激情在线视频
|
不卡久久|
精品国产123
|
色鬼艳魔大战1春荡女淫
|
人人草在线
|
亚洲视频二
|
国产一区免费视频
|
国产精选在线观看
|
插插插91|
a级黄毛片
|
午夜大片|
最近中文字幕av
|
懂色av蜜臀av粉嫩av分享
|
在线看福利影
|
污污网站在线免费观看
|
亚洲视频综合
|
天天毛片|
亚洲精品中文字幕
|
xxx在线视频|
日本精品一区二区三区视频
|
欧美亚洲中文精品字幕
|
黄色av网站免费
|
日本欧美激情
|
亚洲区一区二区三区
|
老鸭资源
|
九九视频在线免费观看
|
天堂av在线资源
|
中文字幕女同女同女同
|
黄av资源
|
捆绑无遮挡打光屁股
|
国产黄色高清视频
|
少妇被躁爽到高潮无码人狍大战
|
污片视频在线观看
|
玩弄人妻少妇500系列
|
美女一区二区三区四区
|
看特级毛片|
欧美一区免费观看
|
日本久久久久久久久久
|
日本极品丰满ⅹxxxhd
|
99精品视频在线
|
久久综合社区
|
欧美丝袜丝交足nylons
|
在线观看毛片网站
|
美女爱爱视频
|
少妇扒开粉嫩小泬视频
|
91免费短视频
|
www.日本高清
|
久久久888|
久久久久久久久久网站
|
www.伊人网|
91精品人妻一区二区三区蜜桃欧美
|
成人av网站在线
|
亚洲青青草
|
超大量吹潮系列合集
|
视频一区在线播放
|
午夜激情免费视频
|
女人做爰全过程免费观看美女
|
性一交一乱一区二区洋洋av
|
亚洲区一区二区三区
|
捆绑无遮挡打光屁股
|
国产91在线视频
|
六月综合
|
特黄色一级片
|
激情小说亚洲图片
|
国产亚洲一区二区三区在线观看
|
韩国三级hd中文字幕
|
天天操天|
日韩一页
|
1024手机在线看片
|
动漫美女无遮挡免费
|
男人操女人网站
|
欧美 日韩 综合
|
99久久99久久精品国产片果冻
|
欧美婷婷|
成人午夜视频在线
|
天天操天天插天天射
|
两女双腿交缠激烈磨豆腐
|
午夜激情免费视频
|
久久超
|
中文字幕一区二区三区精华液
|
www.伊人网|
97看片吧
|
麻豆影音先锋
|
高清不卡毛片
|
人妻少妇精品视频一区二区三区
|
成人丁香婷婷
|
国产又粗又猛又爽又黄的
|
中文字幕一区二区人妻电影
|
尤物视频免费观看
|
女人做爰全过程免费观看美女
|
婷婷激情av|
沟厕沟厕近拍高清视频
|
自拍亚洲欧美
|
国产91小视频
|
国产精品999
|
青青视频在线免费观看
|
色哟哟精品一区
|
精品美女一区二区三区
|
后宫秀女调教(高h,np)
|
超碰人人超碰
|
日一日射一射
|
看特级毛片|
成年人毛片
|
黄色av网站免费
|
欧美成人小视频
|
禁断介护老人中文字幕
|
极度诱惑香港电影完整
|
gogo人体做爰大胆视频
|
人妻精品久久久久中文字幕
|
亚洲午夜一区二区
|
日本性视频网站
|
黄色片www|
国产精品女优
|
免费av播放
|
高h喷水荡肉少妇爽多p视频
|
日韩在线观看视频网站
|
人妻丰满熟妇av无码区hd
|
www狠狠干
|
国语毛片
|
日韩一级黄色大片
|
熟女一区二区三区四区
|
中文字幕亚洲欧美日韩高清
|
一区二区三区黄
|
欧美综合一区
|
51国产视频
|
亚洲美女一区二区三区
|
www.色多多
|
操大爷影院
|
潘金莲一级淫片免费放动漫
|
夜夜视频|
日本一级淫片色费放
|
午夜免费播放观看在线视频
|
国产18在线|
欧美高清hd18日本
|
国产精品久久久久av
|
黄页网站在线播放
|
日本欧美激情
|
99在线视频播放
|
综合网天天
|
国产a电影
|
日本黄色网址大全
|
日韩一区二区三区四区五区六区
|
欧美亚洲国产一区二区三区
|
一区二区免费在线观看
|
澳门黄色一级片
|
老师让我她我爽了好久视频
|
看全色黄大色黄女片18
|
亚洲最新中文字幕
|
做爰视频|
少妇被躁爽到高潮无码人狍大战
|
人妻熟女一区
|
久热在线|
av中文网|
青青免费在线视频
|
日韩欧美精品在线
|
国产精品女优
|
日韩精品久久久久久久
|
精品无码国产一区二区三区51安
|
欧美zzoo|
美国毛片网站
|
97在线播放
|
日韩国产欧美一区二区
|
亚洲高清毛片
|
videosex抽搐痉挛高潮
|
青青草成人在线观看
|
午夜寂寞院
|
日韩少妇
|
中日一级片|
成人自拍av
|
在线观看毛片网站
|
熟睡侵犯の奶水授乳在线
|
亚洲精品一二三
|
哪里可以看毛片
|
成人精品在线视频
|
亚洲天堂午夜
|
日本伊人久久
|
a级片久久
|
噜噜噜久久|
视频网站在线观看18
|
黄色国产视频
|
青青草国产成人99久久
|
免费在线国产视频
|
成人精品在线视频
|
久章草影院
|
www.亚洲国产
|
亚洲天堂av在线播放
|
天天综合亚洲
|
国产精品伊人
|
色婷婷社区|
亚洲天堂av在线播放
|
欧美成人不卡
|
星铁乱淫h侵犯h文
|
欧美在线中文字幕
|
91嫩草视频在线观看
|
伊人久久大香线蕉av一区
|
日韩欧美一级片
|
久久影片
|
丝袜 亚洲 另类 欧美 重口
|
小嫩女直喷白浆
|
高清日韩|
a级片久久
|
成人黄色录像
|
一区二区免费在线观看
|
成人在线激情视频
|
欧美区一区二
|
久久久观看|
99热日韩|
波多野结衣av无码
|
www夜片内射视频日韩精品成人
|
亚洲热视频
|
精品无码久久久久
|
熟女一区二区三区四区
|
91久久国产
|
日韩成人一区二区
|
国产精品天天干
|
娇小的粉嫩xxx极品
天天射天天射
|
国产精品吴梦梦
|
久久综合社区
|
91久久精品日日躁夜夜躁欧美
|
亚洲天堂日本
|
国产亚洲激情
|
黄色小说免费在线观看
|
人成在线
|
在线不卡
|
日韩人妻无码一区二区三区99
|
五月开心婷婷
|
天天射天天射
|
天天综合影院
|
欧美福利视频导航
|
亚洲欧美精品一区二区三区
|
欧美亚洲在线视频
|
青青草青青操
|
白又丰满大屁股bbbbb
|
亚洲精品白浆高清久久久久久
|
亚洲欧美精品一区二区三区
|
三上悠亚 在线观看
|
欧美精品久久久久久
|
精品国产123|
久色网站|
国产精品乱码
|
女女在线|
国产中文字幕一区
|
狠狠干干
|
亚洲精品色午夜无码专区日韩
|
潘金莲一级淫片免费放动漫
|
午夜大片|
日韩少妇
|
日本少妇xxxxx
|
秋霞av鲁丝片一区二区
|
日批国产|
玉女心经 在线
|
亚洲成年人
|
久久久在线
|
av正在播放
|
久久成人一区
|
怡红院av
|
黄污视频在线观看
|
大学生三级中国dvd
亚洲成人精品久久
|
中文字幕亚洲区
|
西西人体大胆4444www
|
成年人免费视频观看
|
国产黄色小说
|
国产色网站
|
九一网站在线观看
|
96视频在线
|
97人人爱
|
国产精品久久影视
|
最近中文字幕av
|
国产日韩在线视频
|
午夜肉体高潮免费毛片
|
911精品国产一区二区在线
|
日韩国产免费
|